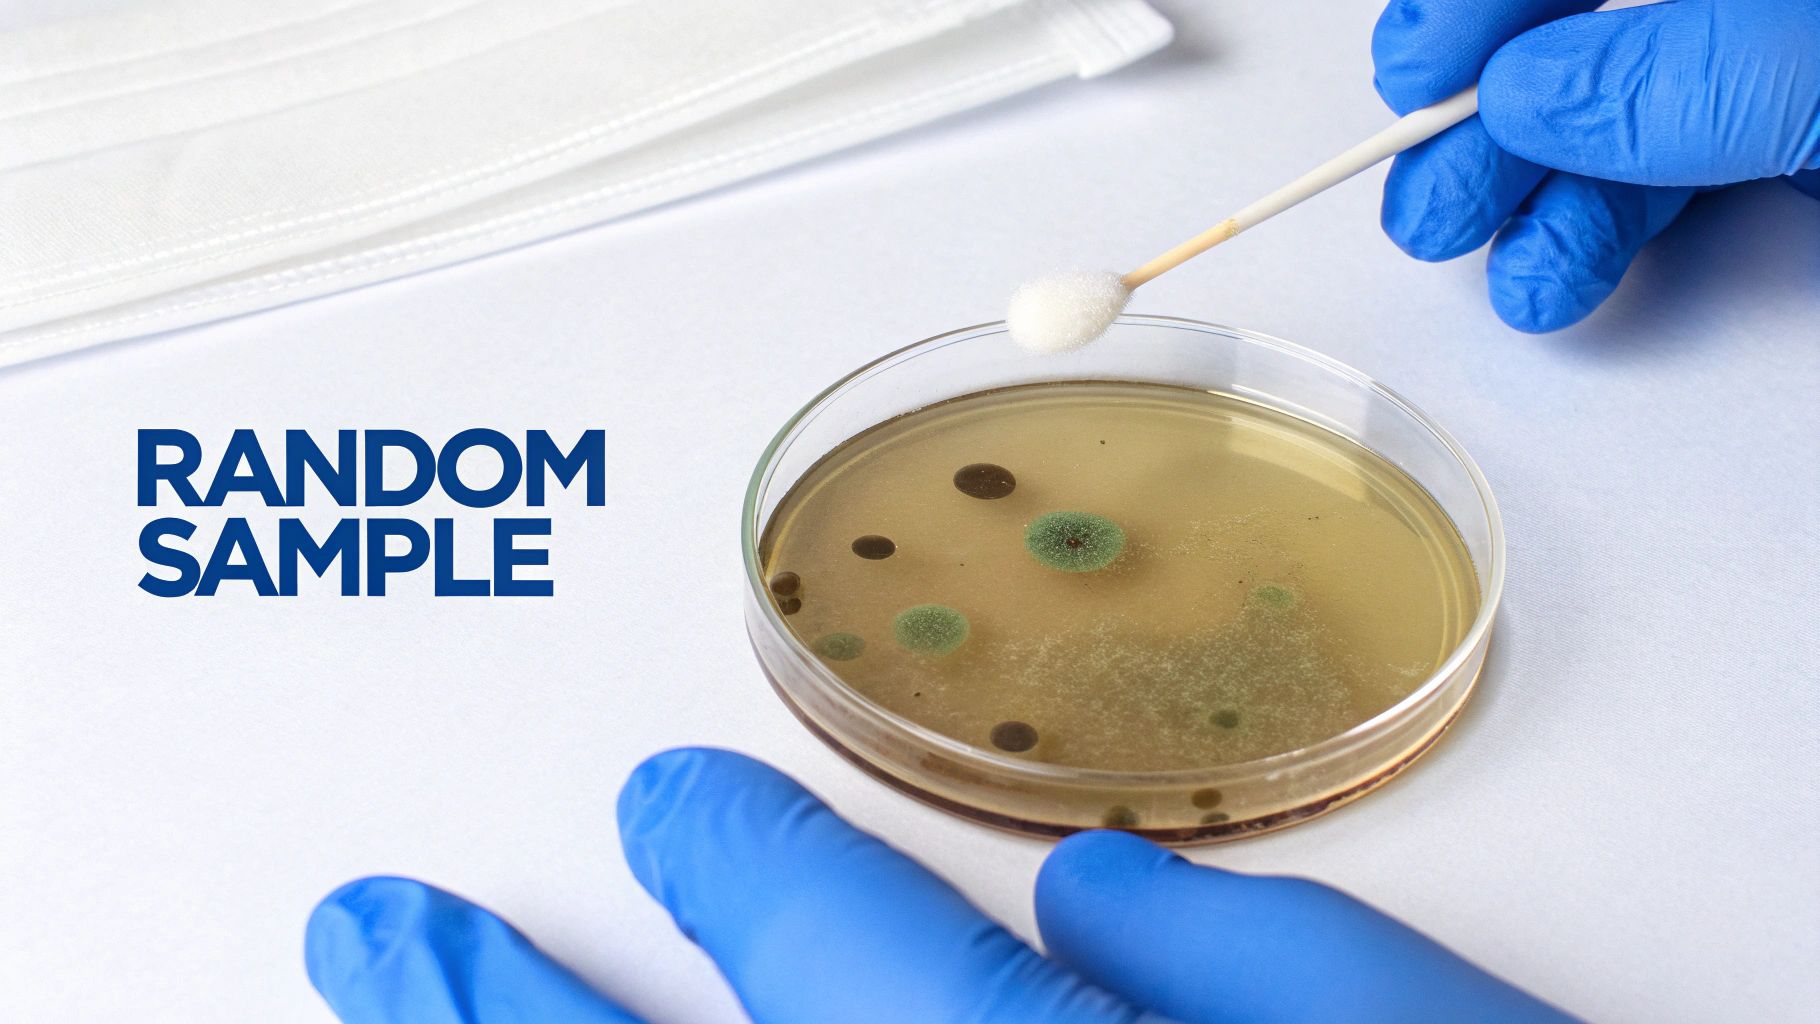
A gloved hand swabs a petri dish with various mold colonies, next to a face mask and "RANDOM SAMPLE" text.

Let's get straight to the point: are those home mold test kits you see at the hardware store accurate? The honest answer is no, at least not in the way that truly matters for your family’s health and your home's safety.
While a DIY kit might confirm that mold spores exist in your home—which, by the way, they do everywhere—they are notoriously unreliable for telling you what you actually need to know: the type of mold, how much is present, and where the heck it's coming from.
Why DIY Mold Tests Give a False Sense of Security
Think of it this way: using a DIY kit is like putting your hand on someone's forehead to check for a fever. Sure, you might get a vague hint that something is warm, but you have no real data. A professional with a calibrated thermometer gives you the precise information you need to take action.
This difference is especially critical for homeowners here in Santa Barbara and Ventura counties, where our coastal humidity creates the perfect breeding ground for hidden mold that these kits almost always miss. Relying on them can lead to a false sense of security, and that's a costly mistake.
These kits just don't have the scientific rigor needed to paint a complete picture of your home's air quality. Their biggest flaws come down to a few key issues:
- No Baseline for Comparison: Mold is everywhere, including outside. A DIY kit doesn't take an outdoor air sample to compare against your indoor air. Without that control sample, you have no way of knowing if your indoor spore counts are actually elevated or just normal.
- Flawed Sampling Methods: Most kits use a simple settling plate, which is basically a petri dish you leave out. It only catches whatever heavy spores happen to fall on it. This completely misses the lighter, more dangerous spores floating in the air you're breathing.
- They Can't Pinpoint the Source: So the test comes back positive. Now what? The kit can't tell you where the mold is growing, which is the single most important piece of the puzzle. Is it behind the shower wall? In the attic? Under the floorboards? The kit leaves you guessing.
To give you a clearer picture, let's break down the key differences between a DIY approach and calling in a professional.
DIY Mold Test Kits vs Professional Inspection
| Feature | DIY Home Mold Test Kit | Professional Mold Inspection |
|---|---|---|
| Accuracy | Low. Prone to false positives and false negatives. | High. Uses calibrated equipment and scientific methods. |
| Scope | Extremely limited. Only tests a tiny, random area. | Comprehensive. Covers the entire home, including hidden areas. |
| Source Identification | None. Cannot locate the source of the mold growth. | Primary goal. Identifies the origin and cause of the problem. |
| Context | Lacks an outdoor control sample for baseline comparison. | Includes an outdoor control sample to determine if indoor levels are abnormal. |
| Data Provided | Vague "yes/no" result, often without identifying mold type. | Detailed lab report identifying mold species and spore counts. |
| Cost | $10-$50 initial cost, plus $40-$70 in optional lab fees. | $500-$1000 for a thorough inspection and sampling. |
| Expertise | Requires no training, leading to common sampling errors. | Conducted by a certified inspector trained to find hidden moisture and mold. |
As you can see, there's really no comparison. While the low upfront cost of a kit is tempting, the information it provides is too incomplete to be useful and can often be misleading.
The Professional Difference
A professional inspection is a different beast entirely. A certified inspector uses specialized equipment—like thermal imaging cameras, moisture meters, and professional air sampling pumps—to follow a methodical process. We're not just looking for mold; we're investigating your home's entire environmental system to find the "why" behind the problem.
If you're curious about what a real assessment looks like, you can learn more about what a mold inspection involves and see why it's a necessary step for truly ensuring a healthy home.
The single greatest danger of a DIY test isn't a false positive—it's a false negative. Believing your home is mold-free when a hidden colony is silently growing can turn a manageable issue into a massive health hazard and an incredibly expensive remediation project down the road.
At the end of the day, that cheap kit from the hardware store might feel like a quick fix, but it simply can't replace the clarity and peace of mind that comes from a comprehensive analysis by a certified professional.
How DIY Mold Tests Work and Why They Fall Short
To really get why those home mold test kits from the hardware store are so unreliable, you first have to understand how they’re designed to work. Most of them are nothing more than a simple petri dish filled with a growth medium, what's known in the industry as a settling plate. The instructions usually tell you to just open it up, leave it in a room for a while, and see what grows.
Right off the bat, this method is fundamentally broken. It’s like trying to figure out what kind of animals live in a forest by looking at a single leaf that happens to fall on your shoe. It’s pure chance.
That little dish can only catch heavy mold spores that happen to fall directly onto its tiny surface. It completely misses the lighter, more dangerous spores that stay airborne—the very ones you’re most likely to breathe in. This kind of random sampling gives you zero meaningful context. It can't tell the difference between a few harmless spores that blew in an open window and a serious, active colony growing inside your walls.
The Limits of DIY Sampling Methods
Some kits also give you a swab to test a spot of visible mold. Sure, this might confirm that the discolored patch you’re looking at is, in fact, mold. But it doesn't tell you anything you didn't already know, and it completely ignores the real question: what’s growing where you can’t see it?
These kits just aren't equipped to tackle the core of a real mold problem because they lack any kind of scientific control or professional-grade tools.
- No Spore Concentration Data: A petri dish can’t tell you the quantity of spores in your air. A professional uses a calibrated air pump to pull a specific volume of air through a collection cassette. This gives you precise data on the spore concentration per cubic meter, which is the key metric for understanding your risk.
- Inability to Find the Source: A positive result from a kit just confirms you have a problem, but it offers no solution. It won’t help you track down the hidden moisture source—that slow leak behind the dishwasher or the condensation in the attic—that's feeding the growth.
- Misleading Results: The limited scope often leads to a false sense of security. If you're curious about different types of kits, you can explore our guide on selecting the best mold test kit for your home, which breaks down why professional tools are always the better choice.
A DIY test simply confirms that mold spores exist in your home—a fact that is true for virtually every single house on Earth. What it can’t do is tell you if the levels are abnormal, where the mold is growing, or how to actually fix the problem.
This total lack of reliable data is why so many industry experts warn people away from them. The truth is, home mold test kits frequently miss up to 90% of problems that are hidden behind walls, under carpets, or inside HVAC systems.
Even leading consumer organizations have given these kits a "Not Recommended" rating because of their "significant flaws," pointing out that they can lull homeowners into a dangerous state of inaction. These kits are ultimately designed to sell a simple answer to what is often a very complex problem. They give you data without context, creating more confusion than clarity and leaving your family’s health up to chance.
The Danger of False Positives and False Negatives
When you use a DIY mold test kit, you're essentially flipping a coin. Unfortunately, both sides of that coin can point you in the wrong direction, leading to two equally risky outcomes: the false positive and the false negative. Neither one gives you the real answers you need to protect your home and family.
A false positive is when the test screams "mold problem!" but there isn't one. Imagine setting one of those petri dishes near an open window on a breezy Goleta afternoon. Of course it's going to collect common outdoor spores that are floating around everywhere. When something grows on the plate, it's easy to panic.
This kind of misleading result creates a ton of unnecessary stress and can send you down a rabbit hole of expensive, pointless actions—all based on flawed data. You might find yourself shelling out for remediation services you never needed, simply because the kit couldn’t tell the difference between normal background spores and a genuine indoor infestation.
The Bigger Threat: A False Negative
While a false positive is a frustrating waste of time and money, the false negative is far more dangerous. This is when the test comes back "clean," giving you a misplaced sense of security while a serious mold problem grows completely unchecked.
Think about this scenario—it happens all the time for homeowners in coastal spots like Montecito. A family starts noticing a faint, musty smell. They grab a DIY kit, run the test, and the results show little to no mold. Relieved, they dismiss the odor and assume everything is fine.
A false negative is the single biggest risk of using a DIY mold test kit. It provides a false sense of security that allows a manageable issue to escalate into a costly and hazardous crisis, compromising a home's structural integrity and its occupants' health.
Months go by, and that faint smell is now a powerful stench you can't ignore. A professional finally comes in and discovers a massive, hidden mold colony thriving inside a wall, quietly fed by a slow plumbing leak. What was once a small, fixable problem has morphed into a major remediation project costing thousands and posing a real health risk that could have been stopped early on.
This is the critical failure of DIY kits. They simply cannot detect hidden mold, which is almost always the most destructive kind. A professional inspector uses specialized tools and a trained eye to conduct comprehensive mold and environmental testing, going far beyond what a petri dish can ever show you. Gambling on an unreliable test just isn't worth it when the stakes—your family’s health and your home's value—are this high.
Why Mold Test Results Need Professional Context
So you used a home mold test kit, sent it to a lab, and got a result. Even if the lab correctly identifies a mold species, that piece of information by itself is practically useless. Why? Because mold spores are a natural, ever-present part of our environment. They're outdoors, they're indoors—finding them in your home is as normal as finding dust on a bookshelf.
The real question isn't, "Is there mold in my house?" The question that actually matters is, "Do I have an abnormal level of mold growing from an indoor source?" That’s a question a DIY kit simply can't answer. It completely lacks the scientific foundation to tell you what the results actually mean.
The Power of a Control Sample
This is where a certified professional changes the game. We start by establishing a scientific baseline. Before even looking at your indoor air, we take a crucial outdoor control sample. This gives us a snapshot of the normal, ambient mold ecology in your specific neighborhood on that particular day.
By comparing your indoor samples to this outdoor baseline, an expert can tell if your home's air is normal or if a hidden leak is feeding an active, indoor colony. A DIY kit completely skips this essential step, leaving you with an isolated piece of data that's impossible to interpret correctly.
Receiving a lab report from a DIY kit that just names a mold species is like a doctor telling you that you have "cells" in your body. It's technically true, but it gives you zero useful information about your health.
The Inaccuracy of Settling Plates
On top of that, the way these kits collect samples is a huge problem. One of the biggest pitfalls of DIY mold tests is their inability to accurately measure airborne spores—the results are often off by a factor of 10 or more.
Professionals use calibrated air pumps that draw a precise 15 liters of air per minute, capturing a true representation of what you're breathing. A settling plate, on the other hand, just passively collects whatever happens to fall on it. It’s a tiny, unrepresentative fraction of what’s actually in your air.
Here in humid coastal areas like Santa Barbara and Ventura Counties, where indoor spore levels can easily spike 200-500% above outdoor baselines after a water event, this level of inaccuracy is downright dangerous.
Without context, a positive result from a kit is just a source of anxiety, not a solution. To make sense of what’s in your air, you need a professional who can provide the complete picture. Learning more about understanding mold test results can help clarify why this professional context is so vital for making informed decisions about your home's safety.
When to Call a Certified Mold Inspector Instead
The low price of a DIY mold kit is certainly tempting. But when you’re dealing with your family’s health, unreliable results are a gamble you just can't afford to take. The real question isn’t if you should use a kit, but knowing when to skip the guesswork entirely and call in a pro.
If any of the following situations sound familiar, your next step should be to pick up the phone, not a test kit from the hardware store. Think of these as your home's way of telling you there's a problem that a simple petri dish won't solve.
Key Triggers for a Professional Inspection
There are a few unmistakable red flags that point to a bigger issue lurking out of sight. Relying on an inaccurate kit when you see these signs can let a small problem spiral into a major health hazard and a financial nightmare.
It's time for a professional assessment if you notice:
- A Persistent Musty Odor: That damp, earthy smell you can’t quite place? It’s the classic calling card of hidden mold. This is especially common in Santa Barbara homes, where the coastal air can fuel mold growth inside wall cavities or tucked away in crawl spaces.
- Unexplained Health Symptoms: Do your allergies, asthma, or other respiratory issues flare up at home but get better when you leave? Unexplained headaches, fatigue, and even skin irritation can all be tied to poor indoor air quality caused by mold.
- Visible Signs of Water Damage: Stains on your ceiling, bubbling paint, or warped flooring are all clear signs of a moisture issue. And where there's moisture, mold isn't far behind. A professional can track down the source of the water and figure out the extent of the damage.
- After a Flood or Major Leak: If your home has been through any kind of significant water event, a mold inspection is non-negotiable. Long after the water is gone, moisture can stay trapped inside building materials, creating the perfect breeding ground for mold.
A professional inspection isn't just about finding mold. It's about finding the moisture source that's letting it grow in the first place. Without fixing the root cause, any cleanup effort is just a temporary fix.
What to Expect From a Professional Assessment
Calling a certified inspector gives you a level of detail and accuracy a DIY kit can’t even begin to touch. Instead of a single, random snapshot, you get a full investigation into the health of your home’s entire ecosystem.
For homeowners in our area, Pacific Mold Pros offers expert mold testing in Santa Barbara, CA to deliver that definitive peace of mind. A certified inspector brings a methodical approach to the table, including:
- A Thorough Visual Inspection: They'll examine your whole property—attics, crawl spaces, HVAC systems, you name it—looking for visible signs of mold and the conditions that help it thrive.
- Advanced Diagnostic Tools: Professionals come equipped with tools like thermal imaging cameras to spot temperature changes that signal hidden moisture behind walls. They also use moisture meters to get precise readings on dampness in drywall, wood, and other materials.
- Strategic and Scientific Sampling: If testing is needed, it’s done right. Samples are collected with calibrated equipment and sent to an accredited, third-party lab for real, scientific analysis.
This professional, data-driven approach is what gives you the actionable information you need to protect your property and ensure your family has a safe, healthy place to live.
Got Questions About Mold Testing? We've Got Answers.
After digging into why those DIY home mold test kits just don't cut it, you probably have a few more things on your mind. That’s perfectly normal. Getting clear on the difference between a cheap kit and a professional assessment is the first step toward making a smart, confident decision for your home. Let's tackle some of the most common questions we hear about cost, the inspection process, and what to look for in a company you can trust.
If DIY Kits Are So Bad, Why Are They on Every Store Shelf?
This is a fantastic and very logical question. The simple answer? DIY mold test kits are cheap to make and they market an easy "solution" to what is actually a very complex problem. They can technically confirm that mold spores are present, which isn't a lie—spores are pretty much everywhere, all the time.
But their marketing conveniently leaves out the most important details. They don't tell you that the results can't identify the type of mold, the quantity in your air, or the source of the problem. You know, the critical information you actually need to solve anything. They offer a deceptively simple answer that gives you a false sense of control, but it completely lacks the scientific accuracy needed for a meaningful assessment.
What's the Real Cost Difference Between a DIY Kit and a Professional Inspection?
A DIY kit might only cost you $10 to $50 upfront (plus whatever lab fees are hiding in the fine print), but a professional mold inspection is a completely different beast. It's a comprehensive service that can range from a few hundred to several hundred dollars, depending on your home's size and the level of testing needed. It’s important to see this not as an expense, but as an investment in certainty.
Think about what you're actually paying for with a professional inspection:
- A certified inspector’s time, training, and experience.
- The use of sophisticated tools like thermal cameras and moisture meters.
- Proper sample collection using calibrated, professional-grade equipment.
- Analysis by an accredited, third-party laboratory.
- A detailed, easy-to-understand report that outlines the findings and gives you clear, actionable next steps.
When you weigh that against the thousands of dollars in remediation and repairs that can result from missing a serious mold problem with a faulty kit, the upfront investment in professional testing suddenly looks a lot more cost-effective.
What Should I Look For in a Professional Mold Inspection Company?
When you’re ready to hire a pro, your top priorities should be credentials and transparency. The first thing to check is that they are fully certified and insured.
Look for key certifications from respected organizations like the IICRC (Institute of Inspection, Cleaning and Restoration Certification) or the ACAC (American Council for Accredited Certification). These aren't just fancy acronyms; they prove the inspector has been properly trained in industry best practices.
Always, always make sure the company uses an independent, third-party accredited lab for sample analysis. This is non-negotiable, as it prevents any conflict of interest. A reputable firm will be transparent about their process, provide a detailed report you can actually understand, and give you clear recommendations without using high-pressure sales tactics. It’s also a great idea to find a local company with solid reviews and a deep understanding of regional challenges, like the specific moisture issues we see in coastal homes here in Santa Barbara and Ventura counties.
Can't I Just Clean Up Visible Mold with Bleach?
This is easily one of the most common—and dangerous—misconceptions about mold. While bleach might kill surface mold on non-porous materials like tile or glass, it’s totally ineffective and often makes things worse on porous materials like drywall, wood, or carpet.
Here's why: on those surfaces, the chlorine in bleach evaporates quickly, but the water component soaks right in. This leftover moisture can actually feed the mold's deeper root structure, causing the problem to come back even stronger. More importantly, just wiping away the visible spots does nothing to fix the underlying moisture issue that allowed the mold to grow in the first place, and it certainly doesn't touch any hidden mold thriving inside your walls. A professional assessment finds the moisture source, figures out the full extent of the contamination, and lays out a proper plan to make sure that mold doesn’t return.